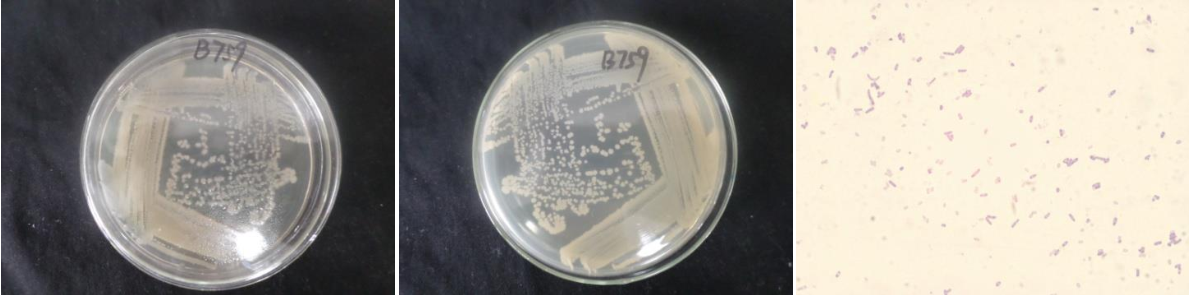

Loading...
| StrainNO | B759 |
| Classification | Bacillus |
| 16s rDNA sequence | CGGCTGGCTCCAAAAGGTTACCTCACCGACTTCGGGTGTTACAAACTCTCGTGGTGTGACGGGCGGTGTGTACAAGACCCGGGA ACGTATTCACCGCGGCATGCTGATCCGCGATTACTAGCGATTCCGGCTTCATGTAGGCGAGTTGCAGCCTACAATCCGAACTGA GAATGGTTTTATGGGATTGGCTTAACCTCGCGGTTTTGCAGCCCTTTGTACCATCCATTGTAGCACGTGTGTAGCCCAGGTCAT AAGGGGCATGATGATTTGACGTCATCCCCACCTTCCTCCGGTTTGTCACCGGCAGTCACCTTAGAGTGCCCAACTAAATGCTGG CAACTAAGATCAAGGGTTGCGCTCGTTGCGGGACTTAACCCAACATCTCACGACACGAGCTGACGACAACCATGCACCACCTGT CACTCTGTCCCCGAAGGGAACCTTCTATCTCTAGAAGTAGCAGAGGATGTCAAGACCTGGTAAGGTTCTTCGCGTTGCTTCGAA TTAAACCACATGCTCCACCGCTTGTGCGGGTCCCCGTCAATTCCTTTGAGTTTCAGTCTTGCGACCGTACTcCCCCAGGCGGAG TGCTTAATGCGTTTGCTGCAGCACTAAAGGGCGGAAACCCTCTAACACTTAGCACTCATCGTTTACGGCGTGGACTACCAGGGT ATCTAATCCTGTTCGCTCCCCACGCTTTCGCGCCTCAGCGTCAGTTACAGACCAGAGAGCCGCCTTCGCCACTGGTGTTCCTCC ACATCTCTACGCATTTCACCGCTACACGTGGAATTCCGCTCTCCTCTTCTGCACTCAAGTTCCCCAGTTTCCAATGACCCTCCA CGGTTGAGCCGTGGGCTTTCACATCAGACTTAAaGGAACCGCCTGCGCGCGCTTTACGCCCAATAATTCCGGACAACGCTTGCC ACCTACGTATTACCGCGGCTGCTGGCACGTAGTTAGCCGTGGCTTTCTGGTTAGGTACCGTCAAGGTACCTGCTTATTTAACAG GTACTTGTTCTTCCCTAACAACAGAGCTTTACGATCCGAAAACCTTCATCACTCACGCGGCGTTGCTCCGTCAGACTTTCGTCCATTGCGGAAGATTCCCTACTGCTGCCTCCCGTAGGAGTCTGGGCCGTGTCTCAGTCCCAGTGTGGCCGATCACCCTCTCAGGTC GGCTACGCATCGTCGCCTTGGTGAGCCGTTACCTCACCAACTAGCTAATGCGCCGCGGGCCCATCCTTGAGTGGTAGCTAAAAG CCACCTTCTAACATATCCTCATGCGAAGATATGTGTTATCCGGTATTAGCTCCGGTTTCCCGGAGTTATCCCCGTCTCAAGGGC AGGTTGCCCACGTGTTACTCACCCGTCCGCCGCTAAGTTTTGAAAAGCAAGCTTTTCAAAACTTCGCTCGACTTGCAT |
| Strain Morphology Photos | |
| Morphological Description | The morphology of Colony round;clam white;concave in the middle;slippy;sticky;waxy;The morphology of strain:Rod;having spore;bias in budding spores |